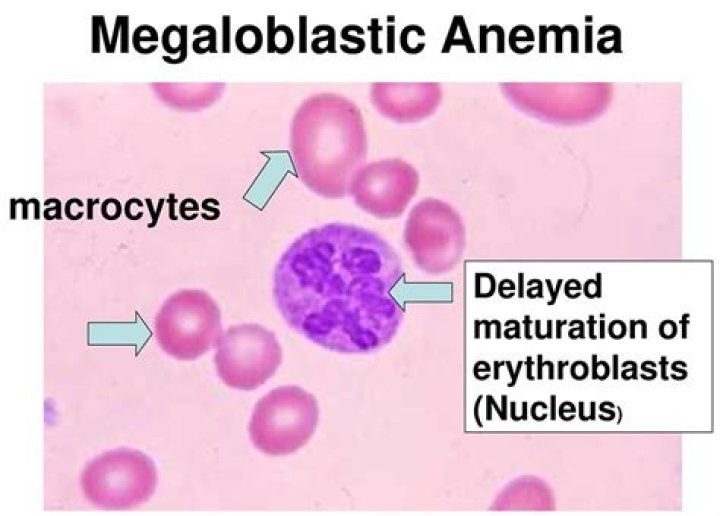

Could clemson join the sec?

The truth is: Despite the extra revenue, the 'conference prestige,' the love from the media and, of course, riding on the shoulders of Alabama, the SEC finds its insecurity in Clemson. So, Clemson won't be joining the SEC.
Did Clemson and Florida State ask to join the SEC?
They formally asked the SEC for membership, and all 14 members voted unanimously to bring on the Big-12 teams. ... Per a reliable source, Clemson+Florida State have reached out to the SEC about joining the conference. The SEC is concerned that streaming numbers for Clemson+Florida State don't bring what Oklahoma+Texas do.
What new teams are joining the SEC?
The University of Texas and the University of Oklahoma have accepted bids to join the Southeastern Conference, the universities announced Friday, after signing off on one of the biggest shifts of money and power in college sports history.
Is the SEC adding teams?
SEC presidents voted on Thursday to admit Texas and Oklahoma into the conference, completing a whirlwind process that began last week and formally setting the stage for another round of Football Bowl Subdivision expansion and realignment.
Did Texas move to the SEC?
After the Southeastern Conference unanimously approved the addition of Texas and Oklahoma to the conference on Thursday, the University of Texas Board of Regents followed suit on Friday morning by unanimously approving Texas' move to the SEC.
'It makes a lot of sense for Clemson to join the SEC' - David Pollack | College Football Live
19 related questions foundWas FSU ever in the SEC?
The University of Florida is the only other SEC member in the state at present although the University of Miami has applied for membership. FSU at present is an independent. It formerly was a member of the old Dixie Conference but dropped out after it began beating other members at football with monotonous regularity.
What Year Will Texas join SEC?
In July, Texas accepted an invitation to join the SEC in 2025, but the move could happen sooner.
Who joined SEC in 2021?
Oklahoma and Texas Officially Join the Southeastern Conference. With the SEC absorbing the two biggest names in the Big 12, the superconference era is under way in college athletics. The superconference era in college athletics has officially kicked off.
What happens if Texas and Oklahoma join SEC?
Once Texas and Oklahoma officially join, the SEC will be comprised of 16 schools, becoming the largest and most powerful college athletic conference in the country.
Will the Big 12 expand?
The ripples of Big 12 expansion began over the summer when Texas and Oklahoma announced a joint move to the SEC, which will be completed by the summer of 2025.
Is Notre Dame in the SEC conference?
Notre Dame is in the ACC in every sport besides football and hockey (Independence, Football and Big Ten, Hockey). The ACC has been memorable for Notre Dame especially last year with the home game vs Clemson and going to the ACC championship.
Why didnt West Virginia join the ACC?
When the Big East began to crumble roughly a decade ago, West Virginia attempted to get into both the ACC and SEC but was denied entrance due to not being in a large TV market and not being a member of the AAU.
Who's joining the Big 12?
The Big 12 Conference announced Friday that BYU, Central Florida, Cincinnati and Houston will become members of the conference no later than 2024-25, bringing the league back to 12 teams.
Is OU moving to the SEC?
The University of Oklahoma Board of Regents met today and unanimously authorized proceedings that allow the university to join the Southeastern Conference (SEC) in 2025 after the expiration of the Big 12 Conference's current media rights agreements.
Can you join SEC before 2025?
NEWS | The @SEC Presidents & Chancellors voted unanimously Thursday to extend membership invitations to the University of Oklahoma and the University of Texas to join the SEC effective July 1, 2025, with competition to begin in all sports for the 2025-26 academic year.
Why is Oklahoma going to the SEC?
Harroz went on to cite the change in television dynamics, the new slew of Name, Image and Likeness legislation, the recruiting landscape and the financial impact of COVID on athletic programs across the country as a few of the many reasons the Sooners are making the move to the SEC.
Is Oklahoma leaving the Big 12?
Six days after news initially broke on July 21 that Texas and Oklahoma were planning to leave the Big 12, the programs said they would not extend their grant of rights beyond 2025 when that current contract expires with ESPN and Fox. ... Bowlsby reiterated that his conference intends to hold the programs to that contract.
Is BYU in the Big 12?
On Sept. 10, BYU was officially invited into the Big 12 Conference. Instead of having just top-ranked Gonzaga coming to Provo, the Cougars will get to host annual games with multiple national champions.
What sport is FSU known for?
Since 1991, Florida State has been a member of the Atlantic Coast Conference. Since joining the conference, FSU has won ninety-six ACC titles and nine national titles including three in football, three in men's track and field, two in soccer, and one in softball.
Who has the most championships in college football?
1. Yale — 18. Yale football has one of the most impressive resumes in the sport, with two of the first three Heisman winners, 100 All-Americans, 28 Hall of Fame inductees, and 18 national championships recognized by the NCAA — the most all time.
Why is Florida State called the Seminoles?
The name was selected specifically to honor the indomitable spirit of the Florida Seminoles — those people whom the Seminole Tribe of Florida refers to as the "few hundred unconquered Seminole men, women and children left — all hiding in the swamps and Everglades of South Florida." FSU's use of the name honors the ...
Will BYU join a conference?
The Big 12 will honor BYU's existing Sunday-play policy, allowing the Cougars to schedule around Sunday competition, much like it has with the West Coast Conference and other conferences previously. BYU will still compete as a member of the WCC for the 2021-22 and 2022-23 seasons.
Who will join the AAC?
The AAC's nine continuing members are: East Carolina, Memphis, South Florida, SMU, Temple, Tulane, Tulsa, Navy (football only) and Wichita State (basketball and Olympic sports only).
Who will AAC add?
AAC officially adds six schools: Charlotte, FAU, North Texas, Rice, UAB, UTSA. Six weeks after losing three teams to the Big 12, the American Athletic Conference's response is official. The league announced Thursday the additions of Charlotte, FAU, North Texas, Rice, UAB and UTSA, all coming from Conference USA.
Is WVU moving to ACC?
Conference realignment talk is starting to pick back up again. Both schools were officially invited and have accepted conference affiliation which is set to begin in 2025. ...